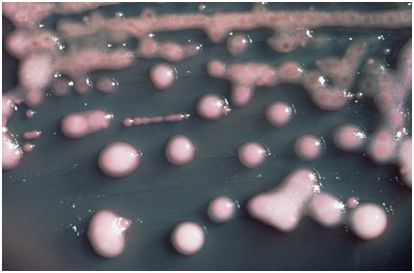

生物学行业动态Industry dynamic
在一项新的研究中,来自美国、日本、以色列、埃及和新加坡的研究人员发现一些证据,表明某些口腔细菌可能导致或加剧肠道疾病。他们在一篇发表在2017年10月20日的Science期刊上的论文中描述了对将在人口腔中发现的细菌导入到小鼠模型肠道内的影响的测试结果。中国科学院免疫学家曹雪涛(Xuetao Cao)院士针对这项研究在同期Science期刊上发表一篇观点类型的论文,提出这项研究可能有朝一日导致人们开发出治疗常见的肠道疾病的新疗法。
肠易激综合征、溃疡性结肠炎和克罗恩病等肠道疾病是并不仅是一种令人讨厌的疾病,它们也能够导致生活质量严重下降,而且在某些情形下甚至是致命性的。基于这个原因,医学科学家们一直在寻找关于它们的原因和治疗方法的答案。在这项新的研究中,这些研究人员发现通常存在于口腔中的细菌与常见的肠道疾病之间存在着可能的关联性。
这些研究人员报道,他们开展这项研究的起因在于他们中的一些成员注意到患有这三种主要的肠道疾病类型之一的患者在其粪便中具有高于正常水平的口腔细菌。因猜测其中可能存在一种关联性,他们开展几项实验以便有助他们更多地了解这两者之间存在的关联性。
在第一项实验中,这些研究人员将来自克罗恩病患者的唾液移植到具有无菌的肠道微生物组的小鼠肠道中。他们发现在一些情形下,这会导致肠道炎症。更仔细的观察表明导致这种炎症的细菌是肺炎克雷伯氏菌(Klebsiella pneumoniae),即一种常见于在人口腔中但很少存在于肠道中的菌株。在另一项实验中,这些研究人员将这种细菌直接导入到健康小鼠的肠道中,结果发现这并不会导致任何问题。当导入克雷伯氏菌(Klebsiella)时,让这些小鼠服用抵抗克雷伯氏菌的抗生素再次会导致肠道炎症。利用来自结肠炎患者的唾液开展的实验也会产生类似的结果。
正如曹雪涛院士指出的那样,这些结果提示着口腔细菌与肠道疾病之间可能存在关联性,不过还需开展更多的研究来证实这一点,但是如果事实证实果真如此,那么在未来治疗肠道疾病的方法可能包括给患者提供口腔消毒剂。
(本文转载生物谷)
上海展辉生物技术有限公司
地址:上海市浦东新区东方路
联系电话:400-689-6719
联系邮箱:3369352092@qq.com
联系我们:
4006896719

扫一扫
关注东洪博元更多动态